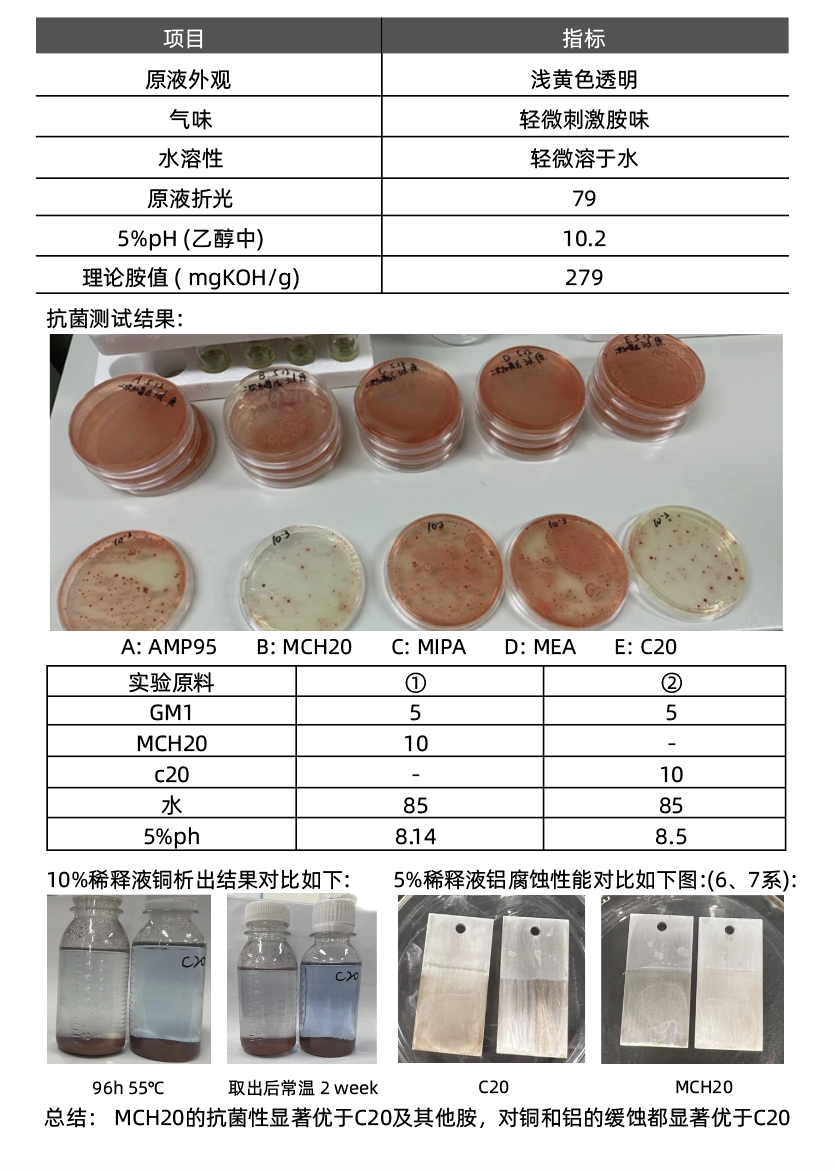

摘要:南京古田化工有限公司将出席本次会议,并展示企业形象及优质产品。
号外!加阿元微信“rhyayuan”,受邀加入润滑油聚焦油粉群,及时了解行业最新资讯~

“CIMSS第八届中国国际金属加工液及表面清洗技术产业大会暨展览展示”将于2023年11月2-3日在江苏扬州举办!大会拓展并深入挖掘润滑油市场的细分产业链,致力于推进发展绿色工业制造业维保新品,构建生态制造体系,涵盖金属加工液、工业清洗、表面活性剂、防锈技术等全产业链。
南京古田化工有限公司将出席本次会议,并展示企业形象及优质产品。热烈欢迎行业同仁前来参加本次会议,共同交流、讨论和分享经验!
参展企业介绍

古田化工成立于2003年,公司现有员工400多人,总部位于南京,在广州设有贸易类子公司——广州古义化工科技有限公司,在天津、武汉、青岛、宁波、成都、西安、福州、沈阳8个城市设有办事处,全国范围内与30多家仓库合作,分布在华东、华北、华南、中南、西部等地区共16个城市。

古田化工亮相2023国展润滑油展
产品介绍
一、多功能叔胺MCH20

二、妥尔油GTO-30


三、过多元饱和醇酯TPO16


四、特殊聚醚PA50


五、混酸GM1


联系方式
南京古田化工有限公司
地址:南京市建邺区嘉陵江东街18号06幢17层
电话: 025-66616267
联系我们
上海国展展览中心有限公司
邮箱:chenfurong@shanghai-intex.com
电话:021-62951239
邮箱:caolina@shanghai-intex.com
电话:021-62952132
更多往届精彩内容可登录展会官网
文章来源:古田化工
本平台致力于行业分享交流,文章不代表平台观点。文字、图片等版权归原作者所有,如不慎侵权,请致电联系删除。





